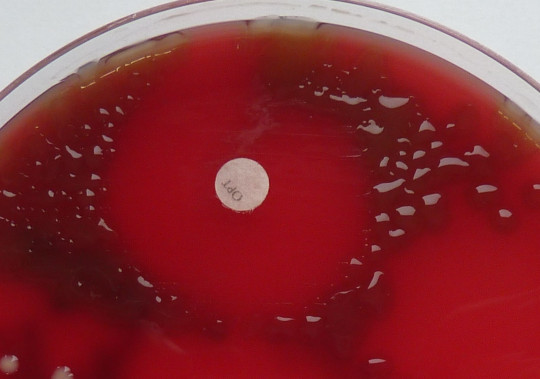
13. Optochinový test – Streptococcus pneumoniae
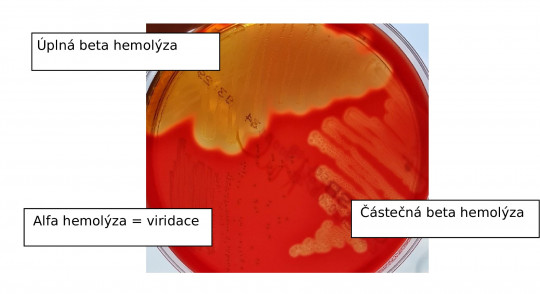
14. Typy hemolýzy
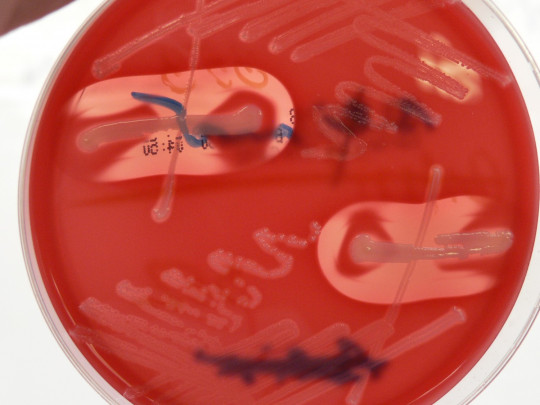
15. CAMP test

6.1
Identifikace bakterií
Identifikace bakterií je založena na hodnocení jejich makroskopické morfologie (tvar, barva kolonií…) a mikroskopické morfologie (koky, tyčinky, grampozitivní, gramnegativní), na fyziologických vlastnostech (vztah ke kyslíku, teplota růstu, …), na biochemických vlastnostech (produkce enzymů, …). Dále lze využít sérotypizaci (určení antigenní struktury), sérologické reakce, detekci produkce toxinů, analýzu hmotnostního spektra jednotlivých komponent. V moderní diagnostice má stále důležitější místo genotypizace (hybridizační a amplifikační techniky, sekvenace apod.).
Rutinně používané testy je možné rozdělit na tzv. jednoduché (sklíčkové, „papírkové“, …) a složitější (zkumavkové, mikrotesty, …). Podrobná identifikace je prováděna komplexem biochemických testů, hmotnostní spektrometrií nebo analýzou nukleových kyselin.
V následujícím přehledu jsou uvedeny základní rutinně používané metody.
6.1.1
Jednoduché identifikační postupy
6.1.1.1
Katalázový test
Principem je štěpení peroxidu vodíku H2O2 na kyslík a vodu. Po smíchání kmene s 3% roztokem H2O2 dojde při pozitivitě testu k bouřlivé tvorbě bublinek.
Příklad použití: stafylokoky jsou kataláza pozitivní, streptokoky kataláza negativní.
6.1.1.2
Průkaz plazmakoagulázy
Rozlišuje se plazmakoaguláza volná a vázaná. Volná se prokazuje koagulací plazmy ve zkumavce, ke králičí plazmě se přidá testovaná kolonie, inkubuje se 4 hodiny při 37 °C. Při produkci volné koagulázy dojde ke sražení plazmy. Je nutné dodržet dobu inkubace, protože při překročení může dojít k rozpuštění sraženiny fibrinolyzinem, který může bakterie současně produkovat. Vázaná koaguláza (tzv. clumping faktor) se prokazuje aglutinací na podložním sklíčku. Do kapky suspenze králičí plazmy a destilované vody se přidá testovaná kolonie, při pozitivitě je během několika minut patrná aglutinace.
+

Obr. 12. Kataláza, koaguláza
6.1.1.3
Optochinový test
Slouží k identifikaci Streptococcus pneumoniae. Na naočkovanou kulturu na krevním agaru se položí disk s optochinem (ethylhydrokuprein). Pozitivní reakce u pneumokoků se projeví po inkubaci vznikem inhibiční zóny okolo disku min 15 mm.
+
Obr. 13. Optochinový test – Streptococcus pneumoniae
6.1.1.4
Rozpustnost ve žluči
Po inokulaci testovaného kmene do zkumavky se žlučovými solemi dochází k aktivaci autolytických enzymů. Kolonie testovaného kmene se rozpustí a zákal se vyčeří. Pozitivní reakce je u S. pneumoniae.
6.1.1.5
Testy na diagnostických proužcích
Na konci plastového proužku je nalepena reakční ploška napuštěná substrátem (event. spolu s indikátorem). Po doteku plošky s kmenem (kolonií) a po stanoveném čase se odečte změna barvy, někdy se přikapává činidlo nebo se proužek ponoří do suspenze bakterie ve FR.
Oxidázový test
Principem je průkaz cytochromoxidázy, pozitivita se projeví zmodráním proužku (např. pseudomonády).
Indoxyl acetátový test
Principem je hydrolýza indoxyl acetátu za vzniku modrého zbarvení. Pozitivní je u Moraxella catarrhalis a kampylobakterů.
PYR – test
Při tomto testu je detekována pyrrolidonylpeptidázová aktivita. Po přidání činidla se pozitivita projeví červeným zbarvením. Pozitivní je u Streptococcus pyogenes a u enterokoků.
Beta-laktamázový test
Provádí se na prožku s nitrocefinem, prokazuje betalaktamázovou aktivitu mikroba.
6.1.1.6
Hodnocení typu hemolýzy na krevním agaru
Hemolýza vzniká narušením erytrocytů pod kolonií nebo v jejím okolí působením hemolyzinů. Síla vyjádření hemolýzy tak závisí na kvalitě krevního agaru. Typy hemolýzy můžeme rozdělit na:
- hemolýzu úplnou, tzv. beta hemolýzu, kdy dojde ke kompletnímu projasnění (např. beta hemolytické streptokoky, působení α hemolyzinu některých stafylokoků, pseudomonády, …),
- hemolýzu neúplnou, kdy je rozpad erytrocytů částečný (např. δ lyzin Staphylococcus aureus, Streptococcus agalactiae),
- viridaci, tzv. alfa hemolýzu,
- jako gama hemolýza je poznačován stav bez hemolýzy.
+
Obr. 14. Typy hemolýzy
Při některých typech testů se využívá vzájemné působení různých hemolyzinů:
- zesílení hemolýzy – v místě styku dvou hemolyzinů vznikne úplná hemolýza (samostatně ji však tyto hemolyziny nezpůsobí).
+
Obr. 15. CAMP test
- potlačení hemolýzy
6.1.1.7
Satelitismus
Toto je jev, kdy určité bakteriální druhy rostou výlučně nebo mnohem intenzivněji v bezprostřední blízkosti kolonií zcela jiného druhu díky metabolitům, které se z tohoto druhu uvolňují. Satelitní bakterie vyžadují k růstu různé faktory. Nejznámější je růst hemofilů v zóně hemolýzy, kdy se růstové faktory uvolňují z rozpadlých erytrocytů. Haemophillus sp. vyžaduje k růstu přítomnost růstových faktorů X (= hemin) a V (= NAD = nicotinamide adenine dinucleotide). Hemin je složka krevního barviva s Fe 3+, NAD je vedlejší produkt metabolismu S. aureus při jeho růstu na krevním agaru a je také obsažen v erytrocytech jako kofaktor.
6.1.2
Složitější identifikační postupy
6.1.2.1
Biochemické identifikační testy
Princip těchto testů je založen na průkazu metabolické aktivity mikroba. Ke kmeni bakterie se přidá určitý substrát (dodaný laboratoří) a po určitém čase se zjišťuje, zda se změnil v jinou chemickou látku – produkt. Většinou jde o katabolickou reakci, výjimečně syntézu. Pozitivita reakce je způsobena přítomností enzymu, který daný kmen produkuje a který tuto reakci katalyzuje. Změna substrátu je buď vidět hned (změna barvy, skupenství…), anebo se pro vizualizaci využije tzv. indikátor reakce (buď už je v reakci od začátku, nebo se přidá po reakci „přikápnutím činidla“). Těchto identifikačních testů je mnoho. V poslední době je identifikace biochemickými testy nahrazována hmotnostní spektrometrií, pokud je to nutné, využívají se biochemické testy komerční. Pricip jednotlivých testů je pro doplnění a přehled uveden v poznámce.
Poznámka
U jednoduchých zkumavkových testů probíhá reakce ve zkumavce, doba inkubace jsou hodiny až den. Substrát je buď tekutý, nebo ve formě šikmo vylitého agaru. Provádí se naočkováním do suspenze nebo hádkem na šikmý agar, event. se do suspenze mikroba vloží substrát ve formě diagnostického proužku.
- Zkvašování cukrů (glukóza, sacharóza, laktóza, manitol, xylóza, …). V pozitivním případě dochází k okyselení a tím ke změně barvy (zežloutnutí půdy v případě použití bromthymolové modři jako indikátoru). Používají se pojmy oxidace a fermentace.
- Arabinóza – štěpení arabinózy. Pozitivita u Enterococcus faecium, negativita Enterococcus faecalis.
- Ornithin – dekarboxylace ornithinu. Pozitivita u enterobakterů.
- Simmons citrát – využití citrátu amonného jako zdroje uhlíku. Pozitivita u klebsiel a enterobakterů.
- ONPG – produkce ortho-nitro-phenyl-galaktosidázy.
- VPT (Voges-Proskauerův test) – tvorba acetoinu z kyseliny pyrohroznové.
- Indol – z tryptofanu vzniká indol, prokáže se přidáním Ehrlichova nebo Kovácsova činidla.
- Tvorba H2S – vyloučení sulfidu olova způsobí zčernání půdy, indikátor citrát železitanoamonný. Pozitivita se projeví zčernáním, pozitivní u salmonel.
- Tvorba plynu.
- Tvorba ureázy – ureáza produkovaná bakteriemi rozkládá močovinu, dochází k alkalizaci prostředí a změně barvy indikátoru.
Složité zkumavkové a kombinované testy využívají kombinace jednotlivých reakcí v jednom procesu. To přináší úsporu času a spotřebního materiálu.
- Hajnova půda (Hajny agar) – současná fermentace glukózy a laktózy, tvorba sirovodíku, tvorba plynu z glukózy, prováděné na šikmém agaru.
- Půda MIU – motility (pohyb) – indol – urea.
- Biochemický klín (Švejcarova plotna) – fermentace glukózy, tvorba sirovodíku, ureázy, štěpení laktózy, manitu, sacharózy, tvorba plynu.
Komerční biochemické testy
Tyto formy testů využívají miniaturizaci do mikrotitračních destiček nebo do speciálních kazet. Složení testů v sadách je voleno podle skupiny identifikovaných bakterií (např. enterobakterie, stafylokoky, streptokoky, …). Do kazety s komerčně připravenými testy se nakape bakteriální suspenze ve fyziologickém roztoku, inkubuje se zpravidla 24, event. 48 hodin. Pak se do některých testů přidají činidla a odečítá se.
+

Obr. 16. Komerční identifikační mikrotesty
6.1.3
Antigenní analýza
Tento typ analýzy využívá antigenní strukturu charakteristickou pro jednotlivé rody a druhy bakterií, případně pro jejich různé sérotypy. Principem je interakce antigenu s protilátkou. Metodou volby pro antigenní analýzu je aglutinace, a to klasická nebo na nosičích. Na destičku (sklo, leštěný karton, …) se nakape testované sérum - obsahuje Ab (protilátka), suspenze bakteriálního kmene ve fyziologickém roztoku se nakape vedle séra, obě kapky se smíchají. Podložkou se kolébá a pozoruje se vznik aglutinátu.
V reakci se využívají polyvalentní séra, která obsahují několik různých typů protilátek. Tak se zařadí testovaný kmen do určité skupiny. Dále se testuje v rámci této skupiny monovalentními séry k přesnému určení antigenní struktury.
Antigenní analýza se používá při typování beta hemolytických streptokoků do skupin, určení séroskupiny u Neisseria meningitidis, odlišení typu b u Haemophilus influenzae, typování salmonel, enteropatogenních E. coli apod.
6.1.4
Hmotnostní spektrometrie
Tato moderní analytická metoda slouží k identifikaci látek a k určení relativní molekulové hmotnosti. Je velmi rychlá a velmi citlivá. Vzorek převádí na ionty, které jsou poté rozděleny podle své hmotnosti a náboje. Výsledné hmotnostní spektrum je zaznamenáno a porovnáno s databází. Hmotnostní spektrometr se skládá ze 3 základních částí: iontového zdroje, hmotnostního analyzátoru a detektoru.
6.1.4.1
Systém MALDI TOF – MS
MALDI Matrix assisted laser desorption/ionization (ionizace/desorpce laserem za účasti matrice) v kombinaci s detektorem doby letu TOF time-of-flight (čas letu) je systém používaný již běžně v rutinních laboratořích. Směs matrice (slabá aromatická kyselina) a vzorku nanesená na vhodný nosič (např. kovovou destičku) je ozařována krátkými pulsy laseru. Ionty analyzované látky jsou urychleny silným elektrickým polem a přes uzemněnou mřížku vstupují do letové trubice, která je vakuovaná. Zde se ionty pohybují rychlostí, která odpovídá jejich hmotnosti a náboji (nižší hmotnost znamená rychlejší pohyb). Měří se doba letu iontů letovou trubicí zaznamenána detektorem. Podle doby dopadu jednotlivých částic je vytvořena křivka (spektrum), která je porovnána s křivkami v databázi známých druhů.
6.1.4.2
Molekulárně-genetické metody
Tyto metody se využívají k identifikaci zejména tam, kde selhávají metody rutinní. Analyzuje se většinou sekvence nukleotidů, která se následně porovnává s databází známých druhů. V posledních letech se uplatňuje stále více celogenomová sekvenace WGS (whole genome sequencing). Tyto postupy se využívají také v epidemiologii při typizaci kmenů a jejich porovnávání. Princip je vysvětlen dále.